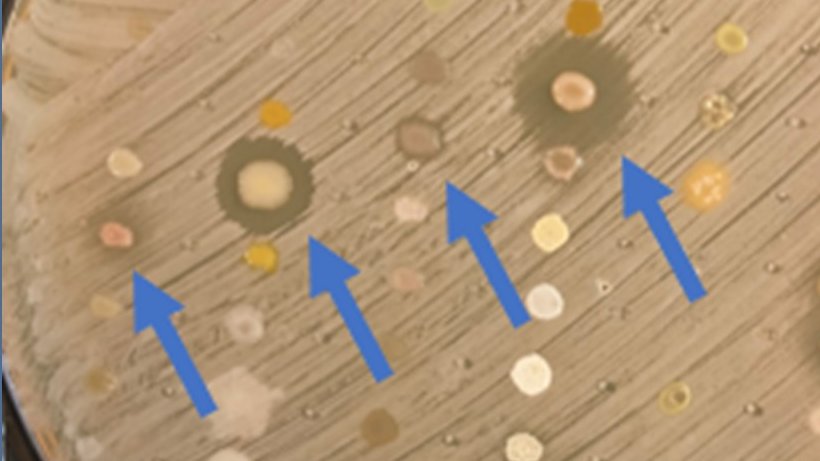
Just published - little editorial on #swabandsend - what we do and why we do it. #AMR #antibiotics 
future-science.com/doi/10.2144/fs…

Prof Mark Fielder
@markusmicrobius
Prof Mark Fielder Professor of medical microbiology @ Kingston University
ID: 21748200
http://microbialmuzzzings.blogspot.com/ 24-02-2009 12:08:19
5,5K Tweet
1,1K Followers
685 Following

A huge thank you to Kingston University for donating 16,600 disposable gloves, 82 regular lab coats, 1,324 safety spectacles, 10 packs of overshoes and 54 disposable face masks to Kingston Hospital and Kingston Health Centre to help protect front-line NHS staff. 👏👏👏


Thanks for speaking to me about why the COVID-19 death rate is so tricky to calculate Prof Mark Fielder, Steffanie Strathdee, PhD 🗡️ 🦠Superbug Slayer🗡️, Mike Tildesley and Dr Aiken of NAME newsweek.com/coronavirus-de…


Please complete our survey "Attitudes Towards Coronavirus Testing During the Pandemic". It is worldwide research, you just need to be 18+, It takes approximately 15 minutes to complete. Please retweet & share with your friends/family! #coronavirus kingstonpcs.eu.qualtrics.com/jfe/form/SV_4N…

The great guys at Kingston Uni are running a survey on public perception of testing for COVID-19 (SARS CoV2) Would you mind sharing widely as it's a really important issue right now and we need to increase our understanding of comms Prof Mark Fielder kingstonpcs.eu.qualtrics.com/jfe/form/SV_4N…

Prof Cloutman-Green🕷 ([email protected]) Prof Mark Fielder Thank you so much for sharing!



The team of health psychology and microbiology experts including Prof. Tushna Vandrevala, Prof Mark Fielder and Philip Terry is inviting people from across the world to take part in the study by completing a public survey: kingstonpcs.eu.qualtrics.com/jfe/form/SV_4N… #Covid_19




We now have a new President @SfAMtweets 🤩🥳@BrendanFGilmore thanks Prof Mark Fielder for welcoming me as a trustee and for always explaining me how the society works 👏👏 😃 Lucy Harper (she/her/hers)



Want to know more about the implications of the recent developments with the Moderna, Oxford/AstraZeneca and Pfizer vaccines? Five key questions about the #COVID19 #vaccines are answered by #KingstonUni’s Professor of medical microbiology Mark Fielder (Prof Mark Fielder)

'A healthy economy simply isn’t possible without healthy people and a healthy planet at its heart.' In this article, my friend and partner of Investor Action on AMR, Fiona Reynolds, explores the role of investors in safeguarding medicine and economies ⤵️